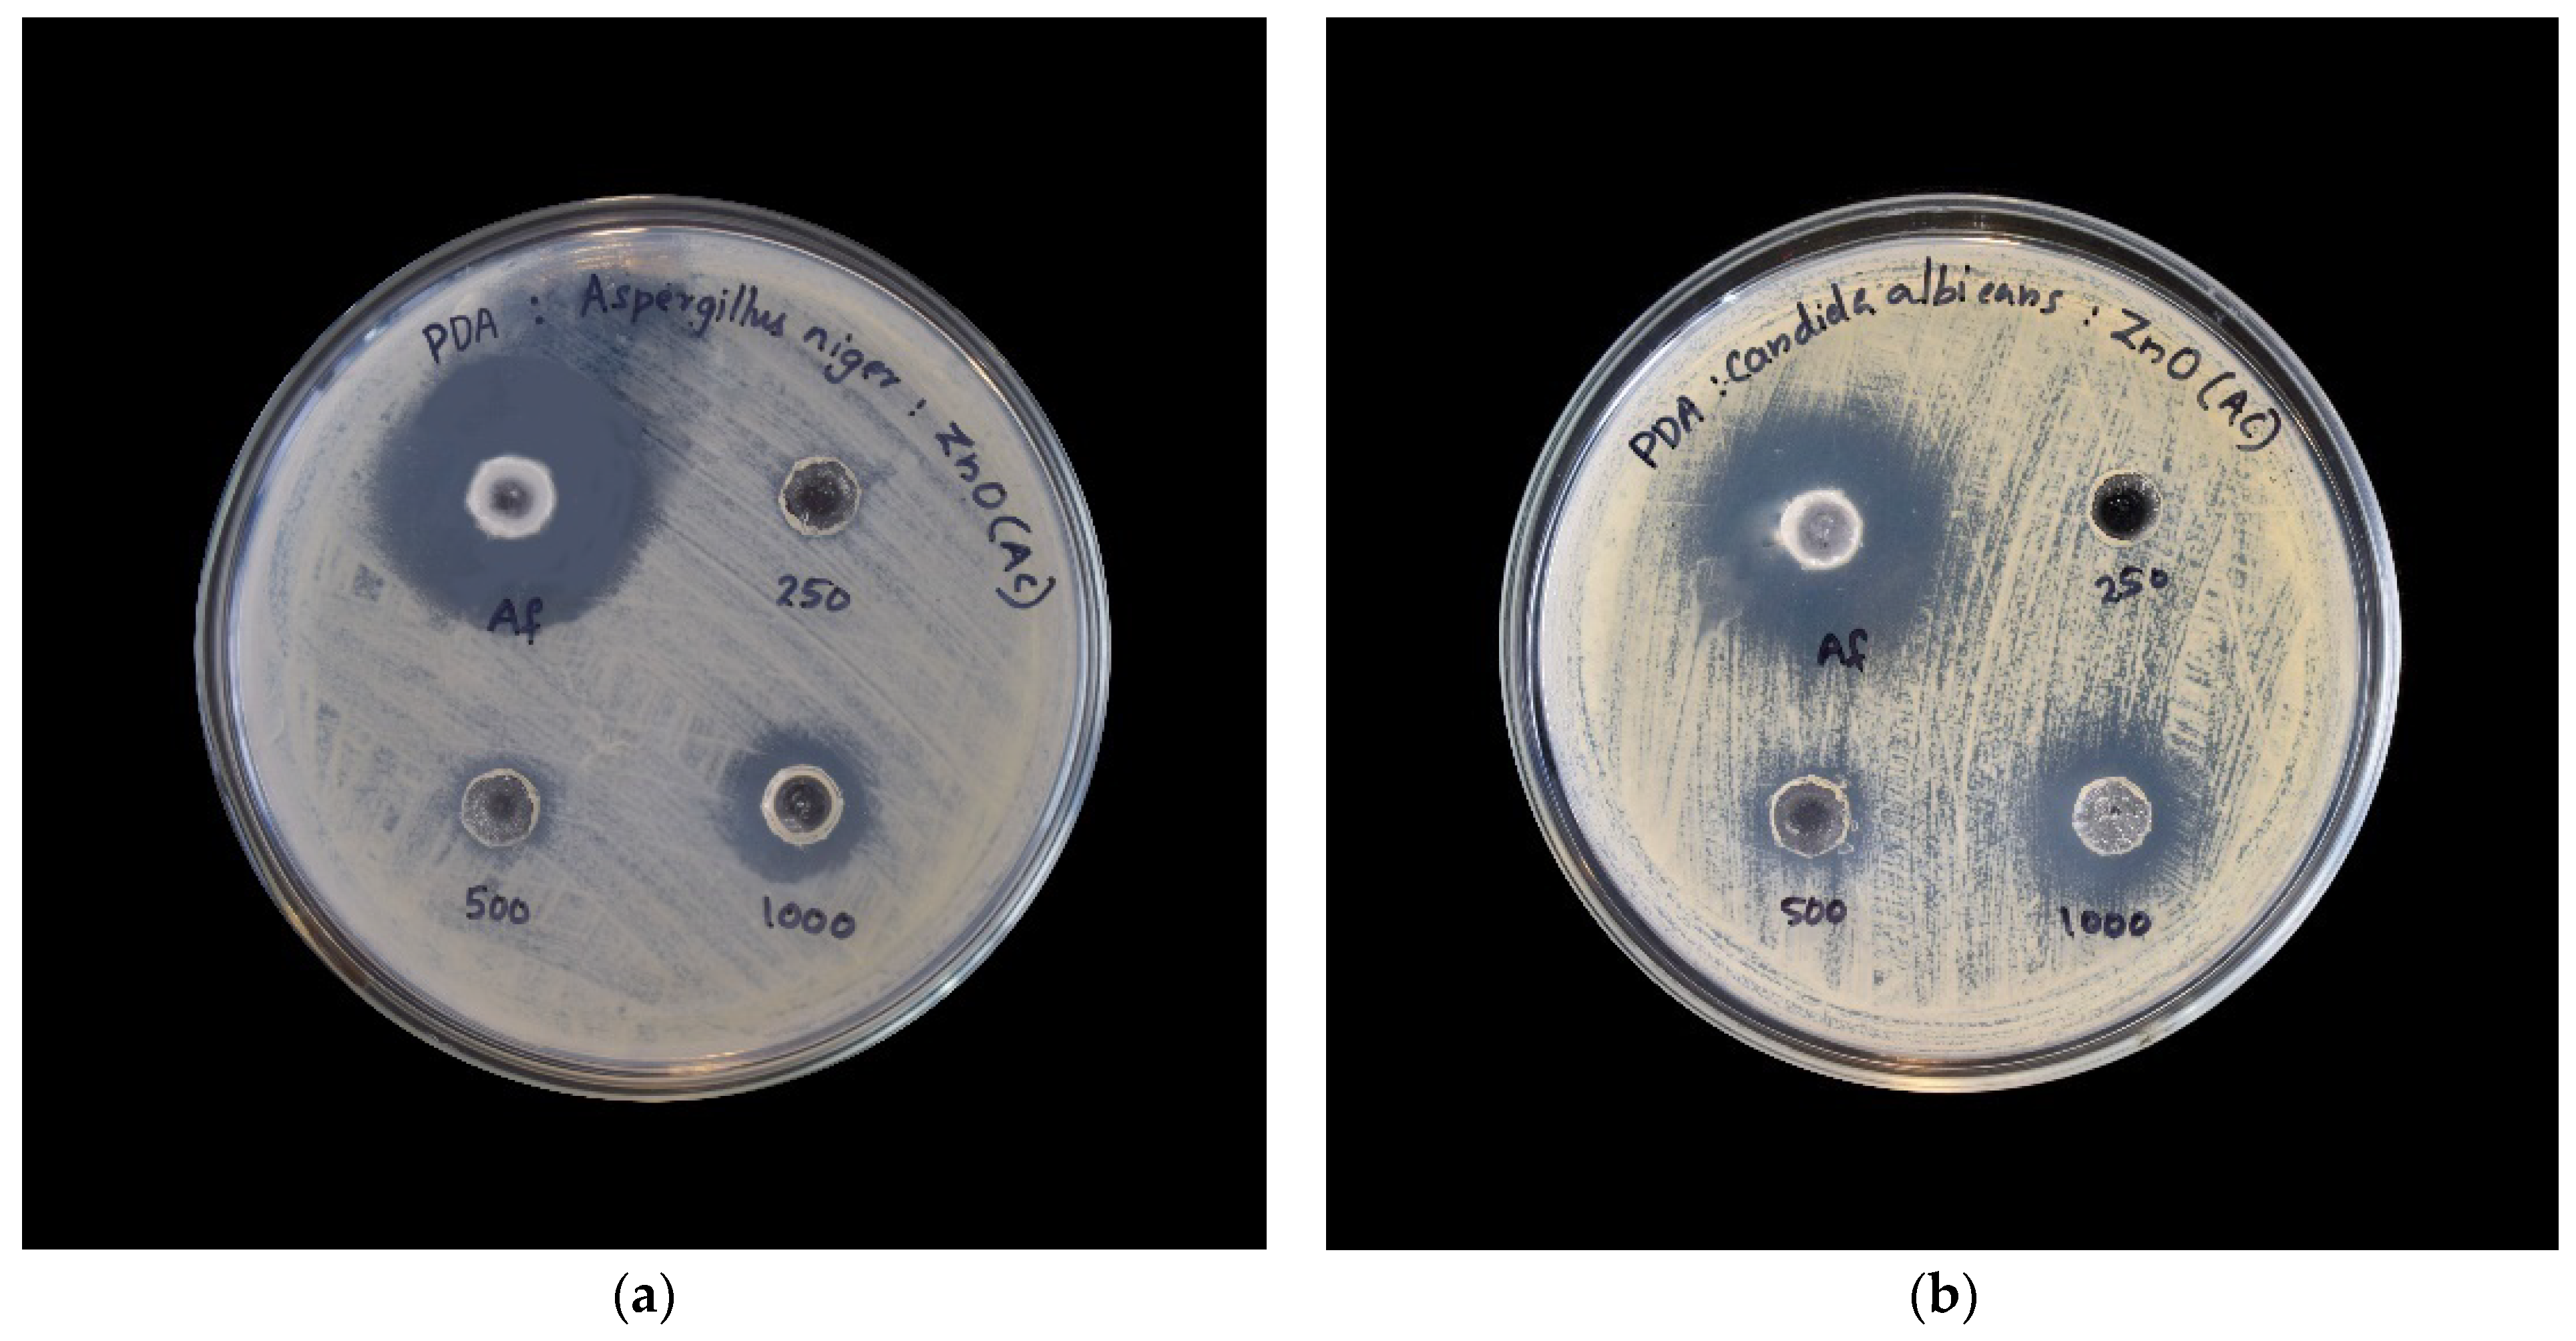
Catalysts 11 01507 g011 550

Synthesis and Characterization of Zinc Oxide Nanoparticles Using Acacia caesia Bark Extract and Its Photocatalytic and Antimicrobial Activities
Abstract
:1. Introduction
2. Results and Discussions
2.1. XRD Analysis
2.2. SEM Analysis
2.3. EDX
2.4. UV-Visible Spectroscopy
2.5. FTIR
2.6. Photocatalytic Activity
2.7. Anti-Inflammatory Activity of ZnO Nanoparticles
2.8. Antimicrobial Activity of ZnO Nanoparticles
2.8.1. Antibacterial Activity of ZnO Nanoparticles
2.8.2. Antifungal Activity of ZnO Nanoparticles
3. Materials and Methods
3.1. Materials for the Synthesis of ZnO Nanoparticles
3.1.1. Preparation of Acacia caesia (L.) Willd Bark Extract
3.1.2. Synthesis of Zinc Oxide Nanoparticles
3.2. Characterization of Zinc Oxide Nanoparticles
3.2.1. X-ray Diffractogram
3.2.2. Scanning Electron Microscopy
3.2.3. Energy Dispersive Spectrometry
3.2.4. UV-VISIBLE Spectrophotometry
3.2.5. Fourier Transform Infrared Spectroscopy
3.2.6. Photocatalytic Activity
3.2.7. Anti-Inflammatory Activity of ZnO Nanoparticles
3.2.8. Antimicrobial Activity of ZnO Nanoparticles
4. Conclusions
Author Contributions
Funding
Data Availability Statement
Acknowledgments
Conflicts of Interest
References
- Poole, C.P., Jr.; Owens, F.J. Introduction to Nanotechnology; John Wiley & Sons: Hoboken, NJ, USA, 2003. [Google Scholar]
- Mazzola, L. Commercializing nanotechnology. Nat. Biotechnol. 2003, 21, 1137–1143. [Google Scholar] [CrossRef] [PubMed]
- Bobo, D.; Robinson, K.J.; Islam, J.; Thurecht, K.J.; Corrie, S.R. Nanoparticle-based medicines: A review of FDA-approved materials and clinical trials to date. Pharm. Res. 2016, 33, 2373–2387. [Google Scholar] [CrossRef]
- Chen, G.; Roy, I.; Yang, C.; Prasad, P.N. Nanochemistry and nanomedicine for nanoparticle-based diagnostics and therapy. Chem. Rev. 2016, 116, 2826–2885. [Google Scholar] [CrossRef]
- Ahmed, S.; Ahmad, M.; Swami, B.L.; Ikram, S. A review on plants extract mediated synthesis of silver nanoparticles for antimicrobial applications: A green expertise. J. Adv. Res. 2016, 7, 17–28. [Google Scholar] [CrossRef] [PubMed] [Green Version]
- Sirelkhatim, A.; Mahmud, S.; Seeni, A.; Kaus, N.H.M.; Ann, L.C.; Bakhori, S.K.M.; Hasan, H.; Mohamad, D. Review on zinc oxide nanoparticles: Antibacterial activity and toxicity mechanism. Nano-Micro Lett. 2015, 7, 219–242. [Google Scholar] [CrossRef] [PubMed] [Green Version]
- Jianrong, C.; Yuqing, M.; Nongyue, H.; Xiaohua, W.; Sijiao, L. Nanotechnology and biosensors. Biotechnol. Adv. 2004, 22, 505–518. [Google Scholar] [CrossRef]
- Holzinger, M.; Le Goff, A.; Cosnier, S. Nanomaterials for biosensing applications: A review. Front. Chem. 2014, 2, 63. [Google Scholar] [CrossRef] [Green Version]
- Awwad, A.M.; Salem, N.M.; Abdeen, A.O. Nanotechnology. Biosynthesis of silver nanoparticles using Olea europaea leaves extract and its antibacterial activity. Nanosci. Nanotechnol. 2012, 2, 164–170. [Google Scholar] [CrossRef] [Green Version]
- McNeil, S.E. Nanotechnology for the biologist. J. Leukoc. Biol. 2005, 78, 585–594. [Google Scholar] [CrossRef]
- Vaseem, M.; Umar, A.; Hahn, Y.-B. ZnO nanoparticles: Growth, properties, and applications. Met. Oxide Nanostruct. Appl. 2010, 5, 1–36. [Google Scholar]
- Meulenkamp, E.A. Synthesis and growth of ZnO nanoparticles. J. Phys. Chem. B 1998, 102, 5566–5572. [Google Scholar]
- Wu, C.; Qiao, X.; Chen, J.; Wang, H.; Tan, F.; Li, S. A novel chemical route to prepare ZnO nanoparticles. Mater. Lett. 2006, 60, 1828–1832. [Google Scholar] [CrossRef]
- Hudlikar, M.; Joglekar, S.; Dhaygude, M.; Kodam, K. Latex-mediated synthesis of ZnS nanoparticles: Green synthesis approach. J. Nanopart. Res. 2012, 14, 865. [Google Scholar] [CrossRef]
- Madhumitha, G.; Elango, G.; Roopan, S.M. Biotechnological aspects of ZnO nanoparticles: Overview on synthesis and its applications. Appl. Microbiol. Biotechnol. 2016, 100, 571–581. [Google Scholar] [CrossRef]
- Vidya, C.; Hiremath, S.; Chandraprabha, M.; Antonyraj, M.L.; Gopal, I.V.; Jain, A.; Bansal, K. Green synthesis of ZnO nanoparticles by Calotropis gigantea. Int. J. Curr. Eng. Technol. 2013, 1, 118–120. [Google Scholar]
- Agarwal, H.; Kumar, S.V.; Rajeshkumar, S. A review on green synthesis of zinc oxide nanoparticles—An eco-friendly approach. Resour.-Effic. Technol. 2017, 3, 406–413. [Google Scholar] [CrossRef]
- Bhuyan, T.; Mishra, K.; Khanuja, M.; Prasad, R.; Varma, A. Biosynthesis of zinc oxide nanoparticles from Azadirachta indica for antibacterial and photocatalytic applications. Mater. Sci. Semicond. Process. 2015, 32, 55–61. [Google Scholar] [CrossRef]
- Mason, C.; Vivekanandhan, S.; Misra, M.; Mohanty, A.K. Engineering. Switchgrass (Panicum virgatum) extract mediated green synthesis of silver nanoparticles. World J. Nano Sci. Eng. 2012, 2, 47. [Google Scholar] [CrossRef]
- Otari, S.; Patil, R.; Nadaf, N.; Ghosh, S.; Pawar, S. Green biosynthesis of silver nanoparticles from an actinobacteria Rhodococcus sp. Mater. Lett. 2012, 72, 92–94. [Google Scholar] [CrossRef]
- Mashrai, A.; Khanam, H.; Aljawfi, R.N. Biological synthesis of ZnO nanoparticles using C. albicans and studying their catalytic performance in the synthesis of steroidal pyrazolines. Arab. J. Chem. 2017, 10, S1530–S1536. [Google Scholar]
- Azizi, S.; Ahmad, M.B.; Namvar, F.; Mohamad, R. Green biosynthesis and characterization of zinc oxide nanoparticles using brown marine macroalga Sargassum muticum aqueous extract. Mater. Lett. 2014, 116, 275–277. [Google Scholar] [CrossRef]
- Anbuvannan, M.; Ramesh, M.; Viruthagiri, G.; Shanmugam, N.; Kannadasan, N. Anisochilus carnosus leaf extract mediated synthesis of zinc oxide nanoparticles for antibacterial and photocatalytic activities. Mater. Sci. Semicond. Process. 2015, 39, 621–628. [Google Scholar] [CrossRef]
- Madan, H.; Sharma, S.; Suresh, D.; Vidya, Y.; Nagabhushana, H.; Rajanaik, H.; Anantharaju, K.; Prashantha, S.; Maiya, P.S. Facile green fabrication of nanostructure ZnO plates, bullets, flower, prismatic tip, closed pine cone: Their antibacterial, antioxidant, photoluminescent and photocatalytic properties. Spectrochim. Acta Part A Mol. Biomol. Spectrosc. 2016, 152, 404–416. [Google Scholar] [CrossRef]
- Kalpana, V.; Devi Rajeswari, V. A review on green synthesis, biomedical applications, and toxicity studies of ZnO NPs. Bioinorg. Chem. Appl. 2018, 2018, 1–12. [Google Scholar] [CrossRef]
- Sorescu, A.-A.; Ion, R.-M.; Ioana, Ş.-B. Green synthesis of silver nanoparticles using plant extracts. In Proceedings of the The 4th International Virtual Conference on Advanced Scientific Results, Zilina, Slovakia, 6–10 June 2016. [Google Scholar]
- Dobrucka, R.; Długaszewska, J. Biosynthesis and antibacterial activity of ZnO nanoparticles using Trifolium pratense flower extract. Saudi J. Biol. Sci. 2016, 23, 517–523. [Google Scholar] [CrossRef] [Green Version]
- Jafarirad, S.; Mehrabi, M.; Divband, B.; Kosari-Nasab, M. Biofabrication of zinc oxide nanoparticles using fruit extract of Rosa canina and their toxic potential against bacteria: A mechanistic approach. Mater. Sci. Eng. C 2016, 59, 296–302. [Google Scholar] [CrossRef]
- Vanathi, P.; Rajiv, P.; Narendhran, S.; Rajeshwari, S.; Rahman, P.K.; Venckatesh, R. Biosynthesis and characterization of phyto mediated zinc oxide nanoparticles: A green chemistry approach. Mater. Lett. 2014, 134, 13–15. [Google Scholar] [CrossRef]
- Raj, L.; Jayalakshmy, E. Biosynthesis and characterization of zinc oxide nanoparticles using root extract of Zingiber officinale. Orient. J. Chem 2015, 31, 51–56. [Google Scholar] [CrossRef]
- Joel, C.; Badhusha, M.S.M. Green synthesis of ZnO Nanoparticles using Phyllanthus embilica Stem extract and their Antibacterial activity. Der Pharm. Lett. 2016, 8, 6. [Google Scholar]
- Chavali, M.S.; Nikolova, M.P. Metal oxide nanoparticles and their applications in nanotechnology. SN Appl. Sci. 2019, 1, 1–30. [Google Scholar] [CrossRef] [Green Version]
- Tereshchenko, A.; Bechelany, M.; Viter, R.; Khranovskyy, V.; Smyntyna, V.; Starodub, N.; Yakimova, R. Optical biosensors based on ZnO nanostructures: Advantages and perspectives. A review. Sens. Actuators B Chem. 2016, 229, 664–677. [Google Scholar] [CrossRef] [Green Version]
- Jiang, J.; Pi, J.; Cai, J. The advancing of zinc oxide nanoparticles for biomedical applications. Bioinorg. Chem. Appl. 2018, 2018, 1062562. [Google Scholar] [CrossRef] [PubMed]
- Xiong, H.M. ZnO nanoparticles applied to bioimaging and drug delivery. Adv. Mater. 2013, 25, 5329–5335. [Google Scholar] [CrossRef]
- Zhang, Z.-Y.; Xiong, H.-M. Photoluminescent ZnO nanoparticles and their biological applications. Materials 2015, 8, 3101–3127. [Google Scholar] [CrossRef]
- Mishra, P.K.; Mishra, H.; Ekielski, A.; Talegaonkar, S.; Vaidya, B. Zinc oxide nanoparticles: A promising nanomaterial for biomedical applications. Drug Discov. Today 2017, 22, 1825–1834. [Google Scholar] [CrossRef]
- Rosi, N.L.; Mirkin, C.A. Nanostructures in biodiagnostics. Chem. Rev. 2005, 105, 1547–1562. [Google Scholar] [CrossRef] [PubMed]
- Jamdagni, P.; Khatri, P.; Rana, J.S. Green synthesis of zinc oxide nanoparticles using flower extract of Nyctanthes arbor-tristis and their antifungal activity. J. King Saud Univ.-Sci. 2018, 30, 168–175. [Google Scholar] [CrossRef] [Green Version]
- Benelli, G.; Kadaikunnan, S.; Alharbi, N.S.; Govindarajan, M. Biophysical characterization of Acacia caesia-fabricated silver nanoparticles: Effectiveness on mosquito vectors of public health relevance and impact on non-target aquatic biocontrol agents. Environ. Sci. Pollut. Res. 2018, 25, 10228–10242. [Google Scholar]
- Babu, R.; Gautham, M.T.; Aswathy, T.; Indu, S.; Nair, A. Pharmacognostic and antibacterial activity evaluation of Acacia caesia (L.) Willd. J. Pharmacogn. Phytochem. 2020, 9, 48–54. [Google Scholar]
- Suriyamoorthy, S.; Subramaniam, K.; Durai, S.J.R.; Wahaab, F.; Chitraselvi, R.P.E. Evaluation of wound healing activity of Acacia caesia in rats. Wound Med. 2014, 7, 1–7. [Google Scholar] [CrossRef]
- Thambiraj, J.; Paulsamy, S. In vitro antioxidant potential of methanol extract of the medicinal plant, Acacia caesia (L.) Willd. Asian Pac. J. Trop. Biomed. 2012, 2, S732–S736. [Google Scholar] [CrossRef]
- Abomuti, M.A.; Danish, E.Y.; Firoz, A.; Hasan, N.; Malik, M.A. Green Synthesis of Zinc Oxide Nanoparticles Using Salvia officinalis Leaf Extract and Their Photocatalytic and Antifungal Activities. Biology 2021, 10, 1075. [Google Scholar] [CrossRef] [PubMed]
- Fu, L.; Fu, Z. Plectranthus amboinicus leaf extract–assisted biosynthesis of ZnO nanoparticles and their photocatalytic activity. Ceram. Int. 2015, 41, 2492–2496. [Google Scholar] [CrossRef]
- Sakthivel, S.; Neppolian, B.; Shankar, M.; Arabindoo, B.; Palanichamy, M.; Murugesan, V. Solar photocatalytic degradation of azo dye: Comparison of photocatalytic efficiency of ZnO and TiO2. Sol. Energy Mater. Sol. Cells 2003, 77, 65–82. [Google Scholar] [CrossRef]
- Lu, J.; Ali, H.; Hurh, J.; Han, Y.; Batjikh, I.; Rupa, E.J.; Anandapadmanaban, G.; Park, J.K.; Yang, D.-C. The assessment of photocatalytic activity of zinc oxide nanoparticles from the roots of Codonopsis lanceolata synthesized by one-pot green synthesis method. Optik 2019, 184, 82–89. [Google Scholar] [CrossRef]
- Chen, S.; Chen, W.; Buyanova, I. Dynamics of donor bound excitons in ZnO. Appl. Phys. Lett. 2013, 102, 121103. [Google Scholar] [CrossRef]
- Teke, A.; Özgür, Ü.; Doğan, S.; Gu, X.; Morkoç, H.; Nemeth, B.; Nause, J.; Everitt, H.O. Excitonic fine structure and recombination dynamics in single-crystalline ZnO. Phys. Rev. B 2004, 70, 195207. [Google Scholar] [CrossRef] [Green Version]
- Aminuzzaman, M.; Ying, L.P.; Goh, W.-S.; Watanabe, A. Green synthesis of zinc oxide nanoparticles using aqueous extract of Garcinia mangostana fruit pericarp and their photocatalytic activity. Bull. Mater. Sci. 2018, 41, 1–10. [Google Scholar] [CrossRef] [Green Version]
- Rafique, M.; Tahir, R.; Gillani, S.; Tahir, M.B.; Shakil, M.; Iqbal, T.; Abdellahi, M. Plant-mediated green synthesis of zinc oxide nanoparticles from Syzygium Cumini for seed germination and wastewater purification. Int. J. Environ. Anal. Chem. 2020, 100, 1–16. [Google Scholar] [CrossRef]
- Spoială, A.; Ilie, C.-I.; Trușcă, R.-D.; Oprea, O.-C.; Surdu, V.-A.; Vasile, B.Ș.; Ficai, A.; Ficai, D.; Andronescu, E.; Dițu, L.-M. Zinc Oxide Nanoparticles for Water Purification. Materials 2021, 14, 4747. [Google Scholar] [CrossRef]
- Mustapha, S.; Ndamitso, M.; Abdulkareem, A.; Tijani, J.; Shuaib, D.; Ajala, A.; Mohammed, A. Application of TiO2 and ZnO nanoparticles immobilized on clay in wastewater treatment: A review. Appl. Water Sci. 2020, 10, 1–36. [Google Scholar] [CrossRef] [Green Version]
- Wang, H.; Zhou, P.; Wang, J.; Wang, Y.; Wei, J.; Zhan, H.; Guo, R.; Zhang, Y. Synthesis and Characterization of Rectorite/ZnO/TiO2 Composites and Their Properties of Adsorption and Photocatalysis for the Removal of Methylene Blue Dye. J. Wuhan Univ. Technol.-Mater. Sci. Ed. 2018, 33, 729–735. [Google Scholar] [CrossRef]
- Weldegebrieal, G.K. Synthesis method, antibacterial and photocatalytic activity of ZnO nanoparticles for azo dyes in wastewater treatment: A review. Inorg. Chem. Commun. 2020, 120, 108140. [Google Scholar] [CrossRef]
- Behnajady, M.A.; Modirshahla, N.; Shokri, M.; Zeininezhad, A.; Zamani, H.A. Enhancement photocatalytic activity of ZnO nanoparticles by silver doping with optimization of photodeposition method parameters. J. Environ. Sci. Health Part A 2009, 44, 666–672. [Google Scholar] [CrossRef]
- Ameen, F.; Dawoud, T.; AlNadhari, S. Ecofriendly and low-cost synthesis of ZnO nanoparticles from Acremonium potronii for the photocatalytic degradation of azo dyes. Environ. Res. 2021, 202, 111700. [Google Scholar] [CrossRef] [PubMed]
- Manoharan, C.; Pavithra, G.; Dhanapandian, S.; Dhamodaran, P.; Shanthi, B. Properties of spray pyrolised ZnO: Sn thin films and their antibacterial activity. Spectrochim. Acta Part A Mol. Biomol. Spectrosc. 2015, 141, 292–299. [Google Scholar] [CrossRef] [PubMed]
- Jiang, Y.; Zhang, L.; Wen, D.; Ding, Y. Role of physical and chemical interactions in the antibacterial behavior of ZnO nanoparticles against E. coli. Mater. Sci. Eng. C 2016, 69, 1361–1366. [Google Scholar] [CrossRef]
- Miri, A.; Mahdinejad, N.; Ebrahimy, O.; Khatami, M.; Sarani, M. Zinc oxide nanoparticles: Biosynthesis, characterization, antifungal and cytotoxic activity. Mater. Sci. Eng. C 2019, 104, 109981. [Google Scholar] [CrossRef] [PubMed]
- Gur, T.; Meydan, I.; Seckin, H.; Bekmezci, M.; Sen, F. Green synthesis, characterization and bioactivity of biogenic zinc oxide nanoparticles. Environ. Res. 2022, 204, 111897. [Google Scholar] [CrossRef] [PubMed]
- Raghupathi, K.R.; Koodali, R.T.; Manna, A.C. Size-dependent bacterial growth inhibition and mechanism of antibacterial activity of zinc oxide nanoparticles. Langmuir 2011, 27, 4020–4028. [Google Scholar] [CrossRef]
- Padmavathy, N.; Vijayaraghavan, R. Enhanced bioactivity of ZnO nanoparticles—An antimicrobial study. Sci. Technol. Adv. Mater. 2008, 9, 035004. [Google Scholar] [CrossRef] [PubMed]
- Zhang, L.; Jiang, Y.; Ding, Y.; Povey, M.; York, D. Investigation into the antibacterial behaviour of suspensions of ZnO nanoparticles (ZnO nanofluids). J. Nanopart. Res. 2007, 9, 479–489. [Google Scholar] [CrossRef]
- Ahmed, B.; Solanki, B.; Zaidi, A.; Khan, M.S.; Musarrat, J. Bacterial toxicity of biomimetic green zinc oxide nanoantibiotic: Insights into ZnONP uptake and nanocolloid–bacteria interface. Toxicol. Res. 2019, 8, 246–261. [Google Scholar] [CrossRef] [PubMed] [Green Version]
- Murali, M.; Kalegowda, N.; Gowtham, H.G.; Ansari, M.A.; Alomary, M.N.; Alghamdi, S.; Shilpa, N.; Singh, S.B.; Thriveni, M.; Aiyaz, M. Plant-Mediated Zinc Oxide Nanoparticles: Advances in the New Millennium towards Understanding Their Therapeutic Role in Biomedical Applications. Pharmaceutics 2021, 13, 1662. [Google Scholar] [CrossRef] [PubMed]
- Nagajyothi, P.; Cha, S.J.; Yang, I.J.; Sreekanth, T.; Kim, K.J.; Shin, H.M. Antioxidant and anti-inflammatory activities of zinc oxide nanoparticles synthesized using Polygala tenuifolia root extract. J. Photochem. Photobiol. B Biol. 2015, 146, 10–17. [Google Scholar] [CrossRef] [PubMed]
- Jayachandran, A.; Aswathy, T.; Nair, A.S. Green synthesis and characterization of zinc oxide nanoparticles using Cayratia pedata leaf extract. Biochem. Biophys. Rep. 2021, 26, 100995. [Google Scholar] [CrossRef] [PubMed]
- Talam, S.; Karumuri, S.R.; Gunnam, N. Synthesis, characterization, and spectroscopic properties of ZnO nanoparticles. Int. Sch. Res. Not. 2012, 2012, 372505. [Google Scholar] [CrossRef] [Green Version]
- Fouda, A.; Salem, S.S.; Wassel, A.R.; Hamza, M.F.; Shaheen, T.I. Optimization of green biosynthesized visible light active CuO/ZnO nano-photocatalysts for the degradation of organic methylene blue dye. Heliyon 2020, 6, e04896. [Google Scholar] [CrossRef]
- El-Belely, E.F.; Farag, M.; Said, H.A.; Amin, A.S.; Azab, E.; Gobouri, A.A.; Fouda, A. Green synthesis of zinc oxide nanoparticles (ZnO-NPs) using Arthrospira platensis (Class: Cyanophyceae) and evaluation of their biomedical activities. Nanomaterials 2021, 11, 95. [Google Scholar] [CrossRef] [PubMed]
- Fakhari, S.; Jamzad, M.; Kabiri Fard, H. Green synthesis of zinc oxide nanoparticles: A comparison. Green Chem. Lett. Rev. 2019, 12, 19–24. [Google Scholar] [CrossRef] [Green Version]
- Alberti, S.; Basciu, I.; Vocciante, M.; Ferretti, M. Experimental and Physico-Chemical Comparison of ZnO Nanoparticles’ Activity for Photocatalytic Applications in Wastewater Treatment. Catalysts 2021, 11, 678. [Google Scholar] [CrossRef]
- Ochieng, P.; Iwuoha, E.; Michira, I.; Masikini, M.; Ondiek, J.; Githira, P.; Kamau, G. Green route synthesis and characterization of ZnO nanoparticles using Spathodea campanulata. Int. J. Biochem. Phys. 2015, 23, 53–61. [Google Scholar]
- Wang, J.; Wang, Z.; Huang, B.; Ma, Y.; Liu, Y.; Qin, X.; Zhang, X.; Dai, Y. Oxygen vacancy induced band-gap narrowing and enhanced visible light photocatalytic activity of ZnO. ACS Appl. Mater. Interfaces 2012, 4, 4024–4030. [Google Scholar] [CrossRef] [PubMed]
- Muhammad, W.; Ullah, N.; Haroon, M.; Abbasi, B.H. Optical, morphological and biological analysis of zinc oxide nanoparticles (ZnO NPs) using Papaver somniferum L. RSC Adv. 2019, 9, 29541–29548. [Google Scholar] [CrossRef] [Green Version]
- Frost, R.; Ding, Z.; Martens, W.; Johnson, T.; Kloprogge, J.T. Molecular assembly in synthesised hydrotalcites of formula CuxZn6—xAl2(OH)16(CO3)·4H2O—A vibrational spectroscopic study. Spectrochim. Acta Part A Mol. Biomol. Spectrosc. 2003, 59, 321–328. [Google Scholar] [CrossRef] [Green Version]
- Chen, C.; Yu, B.; Liu, P.; Liu, J.; Wang, L. Investigation of nano-sized ZnO particles fabricated by various synthesis routes. J. Ceram. Process. Res. 2011, 12, 420–425. [Google Scholar]
- Yu, P.; Yu, H.; Sun, Q.; Ma, B. Filter paper supported nZVI for continuous treatment of simulated dyeing wastewater. Sci. Rep. 2019, 9, 1–8. [Google Scholar]
- Rambabu, K.; Bharath, G.; Banat, F.; Show, P.L. Green synthesis of zinc oxide nanoparticles using Phoenix dactylifera waste as bioreductant for effective dye degradation and antibacterial performance in wastewater treatment. J. Hazard. Mater. 2021, 402, 123560. [Google Scholar] [CrossRef] [PubMed]
- Marin-Flores, C.A.; Rodríguez-Nava, O.C.; García-Hernández, M.; Ruiz-Guerrero, R.; Juárez-López, F.; de Jesús Morales-Ramírez, A. Free-radical scavenging activity properties of ZnO sub-micron particles: Size effect and kinetics. J. Mater. Res. Technol. 2021, 13, 1665–1675. [Google Scholar] [CrossRef]
- Zare, M.; Namratha, K.; Alghamdi, S.; Mohammad, Y.H.E.; Hezam, A.; Zare, M.; Drmosh, Q.A.; Byrappa, K.; Chandrashekar, B.N.; Ramakrishna, S. Novel green biomimetic approach for synthesis of ZnO-Ag nanocomposite; antimicrobial activity against food-borne pathogen, biocompatibility and solar photocatalysis. Sci. Rep. 2019, 9, 1–15. [Google Scholar]
- Surendra, B.; Mallikarjunaswamy, C.; Pramila, S.; Rekha, N. Bio-mediated synthesis of ZnO nanoparticles using Lantana Camara flower extract: Its characterizations, photocatalytic, electrochemical and anti-inflammatory applications. Environ. Nanotechnol. Monit. Manag. 2021, 15, 100442. [Google Scholar]
- Ilves, M.; Palomäki, J.; Vippola, M.; Lehto, M.; Savolainen, K.; Savinko, T.; Alenius, H. Topically applied ZnO nanoparticles suppress allergen induced skin inflammation but induce vigorous IgE production in the atopic dermatitis mouse model. Part. Fibre Toxicol. 2014, 11, 1–12. [Google Scholar] [CrossRef] [Green Version]
- Ramesh, P.; Saravanan, K.; Manogar, P.; Johnson, J.; Vinoth, E.; Mayakannan, M. Green synthesis and characterization of biocompatible zinc oxide nanoparticles and evaluation of its antibacterial potential. Sens. Bio-Sens. Res. 2021, 31, 100399. [Google Scholar] [CrossRef]
- Getie, S.; Belay, A.; Chandra Reddy, A.; Belay, Z. Synthesis and characterizations of zinc oxide nanoparticles for antibacterial applications. J. Nanomed. Nanotechno. S 2017, 8, 1–8. [Google Scholar]
- Sepasgozar, S.M.E.; Mohseni, S.; Feizyzadeh, B.; Morsali, A. Green synthesis of zinc oxide and copper oxide nanoparticles using Achillea Nobilis extract and evaluating their antioxidant and antibacterial properties. Bull. Mater. Sci. 2021, 44, 1–13. [Google Scholar] [CrossRef]
- Agarwal, H.; Menon, S.; Kumar, S.V.; Rajeshkumar, S. Mechanistic study on antibacterial action of zinc oxide nanoparticles synthesized using green route. Chemico-Biol. Interact. 2018, 286, 60–70. [Google Scholar] [CrossRef]
- Soren, S.; Kumar, S.; Mishra, S.; Jena, P.K.; Verma, S.K.; Parhi, P. Evaluation of antibacterial and antioxidant potential of the zinc oxide nanoparticles synthesized by aqueous and polyol method. Microb. Pathog. 2018, 119, 145–151. [Google Scholar] [CrossRef]
- Jayaseelan, C.; Rahuman, A.A.; Kirthi, A.V.; Marimuthu, S.; Santhoshkumar, T.; Bagavan, A.; Gaurav, K.; Karthik, L.; Rao, K.B. Novel microbial route to synthesize ZnO nanoparticles using Aeromonas hydrophila and their activity against pathogenic bacteria and fungi. Spectrochim. Acta Part A Mol. Biomol. Spectrosc. 2012, 90, 78–84. [Google Scholar] [CrossRef]
- Pillai, A.M.; Sivasankarapillai, V.S.; Rahdar, A.; Joseph, J.; Sadeghfar, F.; Rajesh, K.; Kyzas, G.Z. Green synthesis and characterization of zinc oxide nanoparticles with antibacterial and antifungal activity. J. Mol. Struct. 2020, 1211, 128107. [Google Scholar] [CrossRef]
- Siddiqi, K.S.; ur Rahman, A.; Husen, A. Properties of zinc oxide nanoparticles and their activity against microbes. Nanoscale Res. Lett. 2018, 13, 1–13. [Google Scholar] [CrossRef]
- da Silva, B.L.; Abuçafy, M.P.; Manaia, E.B.; Junior, J.A.O.; Chiari-Andréo, B.G.; Pietro, R.C.R.; Chiavacci, L.A. Relationship between structure and antimicrobial activity of zinc oxide nanoparticles: An overview. Int. J. Nanomed. 2019, 14, 9395. [Google Scholar] [CrossRef] [Green Version]
- Tan, S.; Sun, X.; Zhang, X.; Chua, S.; Chen, B.; Teo, C. Cluster coarsening in zinc oxide thin films by postgrowth annealing. J. Appl. Phys. 2006, 100, 033502. [Google Scholar] [CrossRef]
- Baharudin, K.B.; Abdullah, N.; Derawi, D. Effect of calcination temperature on the physicochemical properties of zinc oxide nanoparticles synthesized by coprecipitation. Mater. Res. Express 2018, 5, 125018. [Google Scholar] [CrossRef]
- Ismail, A.; Menazea, A.; Kabary, H.A.; El-Sherbiny, A.; Samy, A. The influence of calcination temperature on structural and antimicrobial characteristics of zinc oxide nanoparticles synthesized by Sol–Gel method. J. Mol. Struct. 2019, 1196, 332–337. [Google Scholar] [CrossRef]
- Viezbicke, B.D.; Patel, S.; Davis, B.E.; Birnie, D.P., III. Evaluation of the Tauc method for optical absorption edge determination: ZnO thin films as a model system. Phys. Status Solidi B 2015, 252, 1700–1710. [Google Scholar] [CrossRef]
- Walker, M.C.; Gierse, J.K. In vitro assays for cyclooxygenase activity and inhibitor characterization. In Cyclooxygenases; Springer: Berlin/Heidelberg, Germany, 2010; pp. 131–144. [Google Scholar]
- Álvarez-Chimal, R.; García-Pérez, V.I.; Álvarez-Pérez, M.A.; Arenas-Alatorre, J.Á. Green synthesis of ZnO nanoparticles using a Dysphania ambrosioides extract. Structural characterization and antibacterial properties. Mater. Sci. Eng. C 2021, 118, 111540. [Google Scholar] [CrossRef]

| Sl. No. | 2Ө | FWHM (β) | Miller Indices | Particle Size D (nm) |
|---|---|---|---|---|
| 1 | 31.61 | 0.0039 | (100) | 36.48 |
| 2 | 34.28 | 0.0039 | (002) | 36.74 |
| 3 | 36.10 | 0.0043 | (101) | 33.56 |
| 4 | 47.40 | 0.0047 | (102) | 31.94 |
| 5 | 56.45 | 0.0055 | (110) | 28.46 |
| 6 | 62.72 | 0.0063 | (103) | 25.69 |
| 7 | 67.80 | 0.0055 | (112) | 30.21 |
| 8 | 68.93 | 0.0047 | (201) | 35.48 |
| Notation | Concentration of MB (mg/mL) | Concentration of ZnO (mg/mL) | Rate Constant | Intercept | R2 |
|---|---|---|---|---|---|
| A | 0.06 | 0.2 | 3.16 × 10−4/s | 0.029 | 0.98 |
| B | 0.06 | 0.1 | 1.75 × 10−4/s | 0.071 | 0.96 |
| C | 0.03 | 0.2 | 2.19 × 10−4/s | 0.083 | 0.90 |
| D | 0.03 | 0.1 | 1.13 × 10−4/s | 0.015 | 0.99 |
| ZnO Nanoparticle Concentration (μg) | Zone of Inhibition (mm) (Diameter) | |
|---|---|---|
| E. coli | S. aureus | |
| 250 | 15 | 11 |
| 500 | 17 | 12 |
| 1000 | 18 | 13 |
| Streptomycin (100 µg) | 25 | 25 |
| ZnO Nanoparticles Concentration (µg) | Zone of Inhibition (mm) (Diameter) | |
|---|---|---|
| Aspergillus niger | Candida albicans | |
| 250 | 11 | Nil |
| 500 | 12 | 12 |
| 1000 | 14 | 15 |
| Standard Drug Clotrimazole (100 µg) | 29 | 27 |
Publisher’s Note: MDPI stays neutral with regard to jurisdictional claims in published maps and institutional affiliations. |
© 2021 by the authors. Licensee MDPI, Basel, Switzerland. This article is an open access article distributed under the terms and conditions of the Creative Commons Attribution (CC BY) license (https://creativecommons.org/licenses/by/4.0/).
Share and Cite
Ashwini, J.; Aswathy, T.R.; Rahul, A.B.; Thara, G.M.; Nair, A.S. Synthesis and Characterization of Zinc Oxide Nanoparticles Using Acacia caesia Bark Extract and Its Photocatalytic and Antimicrobial Activities. Catalysts 2021, 11, 1507. https://doi.org/10.3390/catal11121507
Ashwini J, Aswathy TR, Rahul AB, Thara GM, Nair AS. Synthesis and Characterization of Zinc Oxide Nanoparticles Using Acacia caesia Bark Extract and Its Photocatalytic and Antimicrobial Activities. Catalysts. 2021; 11(12):1507. https://doi.org/10.3390/catal11121507
Chicago/Turabian StyleAshwini, Jayachandran, Thankamani Ravikumar Aswathy, Anil Babu Rahul, Gautham M. Thara, and Achuthsankar S. Nair. 2021. "Synthesis and Characterization of Zinc Oxide Nanoparticles Using Acacia caesia Bark Extract and Its Photocatalytic and Antimicrobial Activities" Catalysts 11, no. 12: 1507. https://doi.org/10.3390/catal11121507
APA StyleAshwini, J., Aswathy, T. R., Rahul, A. B., Thara, G. M., & Nair, A. S. (2021). Synthesis and Characterization of Zinc Oxide Nanoparticles Using Acacia caesia Bark Extract and Its Photocatalytic and Antimicrobial Activities. Catalysts, 11(12), 1507. https://doi.org/10.3390/catal11121507
